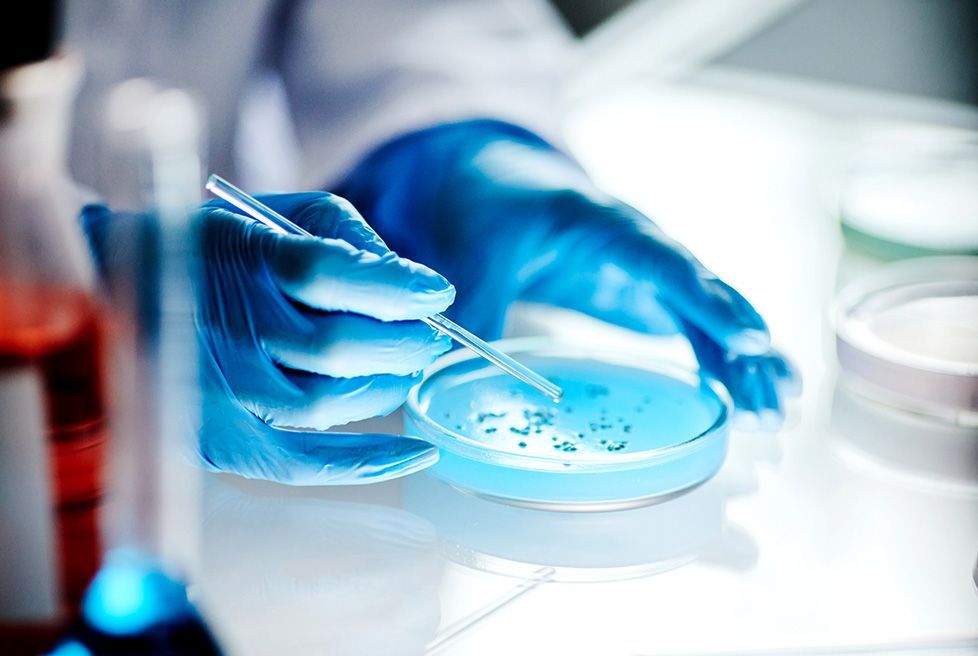
LABORATORIO CONFAR - Challenge test y evaluación de protección antimicrobiana – ISO 11930

En CONFAR impulsamos la calidad y cumplimiento normativo de cosméticos, farmacéuticos y dispositivos médicos en México. Laboratorio acreditado ante la Entidad Mexicana de Acreditación (ema) bajo la norma NMX-EC-17025-IMNC-2018 (ISO/IEC 17025:2017), Acreditación No. Q-1893-296/25.
Laboratorio de Control Farmacéutico en México
con Acreditación ISO 17025 ante ema
Laboratorio acreditado ante la Entidad Mexicana de Acreditación (ema) en México
En CONFAR (Laboratorio de Control Farmacéutico, S.C.) contamos con la acreditación Q-1893-296/25 otorgada por la Entidad Mexicana de Acreditación bajo la norma NMX-EC-17025-IMNC-2018 (ISO/IEC 17025:2017). Esta acreditación garantiza competencia técnica, trazabilidad de resultados y cumplimiento regulatorio en la rama Química.
Si tu empresa necesita demostrar calidad ante COFEPRIS, auditorías internas o clientes internacionales, trabajamos con métodos normativos reconocidos que respaldan cada resultado.
¿Por qué elegir CONFAR como tu laboratorio de ensayo en México?
Laboratorio acreditado Q-1893-296/25 ante ema
Métodos oficiales y normativos actualizados
Atención técnica especializada
Cobertura para la industria cosmética, farmacéutica, sanitizante y dispositivos médicos
Soporte documental para auditorías y registros sanitarios.
CONFAR funciona como aliado estratégico para fabricantes que buscan certeza técnica y respaldo normativo en México.
Preguntas frecuentes sobre análisis microbiológicos y fisicoquímicos
-
¿Qué industrias atiende CONFAR en México?
Atendemos a la industria relacionada con cosméticos, productos de belleza, farmacéuticos, sanitizantes, limpieza, dispositivos médicos y análisis ambientales en áreas controladas.
-
¿Las pruebas están acreditadas ante ema?
Sí. Diversas pruebas se encuentran acreditadas bajo la acreditación Q-1893-296/25 ante la Entidad Mexicana de Acreditación (ema).
-
¿Pueden apoyar en auditorías o inspecciones sanitarias?
Entregamos reportes técnicos listos para auditorías internas, regulatorias o procesos de exportación.
Servicios de análisis microbiológicos en México para cosméticos y farmacéuticos
Realizamos Challenge Test conforme a ISO 11930:2019 para validar la eficacia del sistema conservador en productos cosméticos. Este análisis reduce riesgos sanitarios, evita retiros de producto y fortalece tu expediente técnico ante autoridades regulatorias.
Challenge test y evaluación de protección antimicrobiana – ISO 11930
Evaluamos la carga microbiana total en cosméticos y productos de cuidado personal conforme a NOM-089-SSA1-1994. Ideal para fabricantes que buscan prevenir sanciones y proteger su marca.
Determinación del contenido microbiano en productos de belleza – NOM-089-SSA1-1994
Ejecutamos pruebas de esterilidad (MGA 0381), endotoxinas bacterianas (MGA 0316) y monitoreo microbiológico ambiental bajo FEUM e ISO 14698-1. Garantiza condiciones seguras en procesos farmacéuticos y dispositivos médicos.
- Actividad Antimicrobiana (Reto Microbiano) – MGA-DM 0041
- Coliformes Totales y E. coli en agua – EPA-MET 1604
- Salmonella spp. – NOM-210-SSA1-1-2014
- Pseudomona aeruginosa – NOM-201-SSA1-2015
- Cuenta Total de Mesófilos Aerobios – NOM-201-SSA1-201
Esterilidad, endotoxinas y control ambiental en áreas controladas
Análisis fisicoquímicos acreditados para cumplimiento normativo en México
Complementamos el control microbiológico con análisis fisicoquímicos acreditados ante ema. Validamos parámetros críticos que impactan estabilidad, seguridad y etiquetado.
Contenido mínimo – MGA-0221
pH – MGA-0701
Metales pesados – MGA-0561 / NOM-117-SSA1-1994
Hermeticidad – MGA-0486
Densidad relativa – MGA-0251
Cloro residual libre – NOM-201-SSA-1-2015
Sólidos disueltos totales – NMX-AA-034-SCFI-2015
Cada prueba genera resultados trazables y reportes listos para auditoría.
Recolección y toma de muestras 24/7
Nuestro equipo opera 24/7 para la toma y recolección de muestras en planta. Aplicamos protocolos normativos que aseguran integridad, cadena de custodia y confiabilidad analítica. Este servicio reduce tiempos logísticos y facilita inspecciones regulatorias.
Solicita tu análisis a un laboratorio
acreditado en México
Protege tu marca y cumple con la normativa sanitaria en México. Solicita información técnica o cotización personalizada directamente en el sitio oficial.
Visita el sitio oficial y solicita una cotización